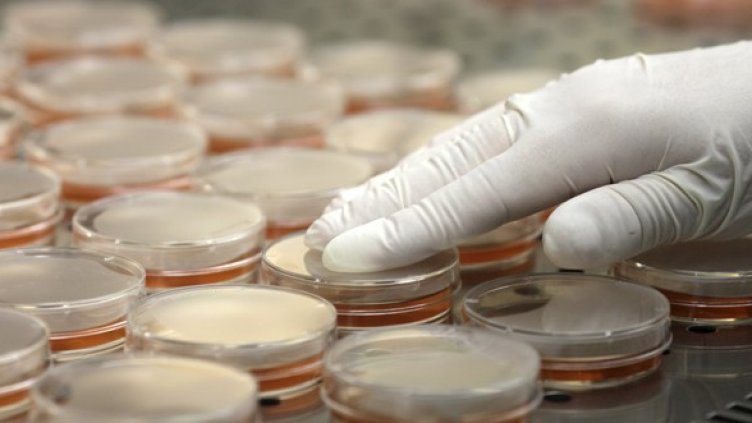
Снимка: Reuters

Европейският съюз е предал на Русия щама на бактерията Е.коли предизвикала в Европа епидемия от остра чревна инфекция, съобщи Интерфакс.
Щамът е бил изпратен от лабораторията на ЕС в Рим. Той ще бъде доставен в научния център на руската санитарна служба в Оболенск.
„Това е принципно нова ситуация, която ни дав авъзможност за собествни научни изследвания, казаха от руската санитарна служба.
Във връзка с разпрозстранението на щама Русия въведе забрана за внос на някои европейски продукти.
В резултат от инфекцията от началото на май починаха 39 души. Германските власти идентицифираха миналата седмица като източник на заразата кълнове на бобови култури. Вчера бе съобщено, че бактерията е открита в поток близо до Франкфурт
Това се случи Dnes, за важното през деня ни последвайте и в Google News Showcase.

Кадър на деня за 20 юни
Кадър на деня за 20 юни  Как ястребовата политика на централните банки влияе на пазарите на акции?
Как ястребовата политика на централните банки влияе на пазарите на акции?  Преломен момент настъпва във войната в Украйна
Преломен момент настъпва във войната в Украйна  Енергийният министър очаква споразумението с "Боташ" да се предоговори до един-два месеца
Енергийният министър очаква споразумението с "Боташ" да се предоговори до един-два месеца  Империята на ислямската гвардия ще спечели най-много от отмяна на санкциите срещу Иран
Империята на ислямската гвардия ще спечели най-много от отмяна на санкциите срещу Иран  Иран пак затвори Ормузкия проток
Иран пак затвори Ормузкия проток 
 Венеция удря туристите с нова шокова такса до 50 евро
Венеция удря туристите с нова шокова такса до 50 евро  14-годишен футболист почина по време на мач
14-годишен футболист почина по време на мач  Шок за Бразилия: Световното приключи за Рафиня
Шок за Бразилия: Световното приключи за Рафиня  Заповед на Тръмп промени емблематичния басейн до Мемориала на Линкълн (СНИМКИ)
Заповед на Тръмп промени емблематичния басейн до Мемориала на Линкълн (СНИМКИ)  Вулканът Семеру изригна: Миньор е с тежки изгаряния
Вулканът Семеру изригна: Миньор е с тежки изгаряния  Нидерландия гледа смело към елиминациите след разгром над Швеция
Нидерландия гледа смело към елиминациите след разгром над Швеция 
 Стана ясна заплатата на легендарен треньор, ако се върне в Атина
Стана ясна заплатата на легендарен треньор, ако се върне в Атина  Спортът по телевизията днес, 21 юни
Спортът по телевизията днес, 21 юни  Мачовете по телевизията днес, 21 юни
Мачовете по телевизията днес, 21 юни  Германия удари Кот д'Ивоар в 94-ата минута и спря прокобата
Германия удари Кот д'Ивоар в 94-ата минута и спря прокобата  ПО МИНУТИ: Германия - Кот д'Ивоар 2:1
ПО МИНУТИ: Германия - Кот д'Ивоар 2:1  Валенсия нашамари Барса в баскетболния финал в Испания
Валенсия нашамари Барса в баскетболния финал в Испания 
 Седмична таро прогноза за 22 - 28 юни
Седмична таро прогноза за 22 - 28 юни  Дневен хороскоп за 21 юни, неделя
Дневен хороскоп за 21 юни, неделя  Седмична нумерологична прогноза за 22 - 28 юни
Седмична нумерологична прогноза за 22 - 28 юни  5 любопитни ритуала за 21 юни, когато настъпва астрономическото лято
5 любопитни ритуала за 21 юни, когато настъпва астрономическото лято  3 слънчеви десерта за 21 юни – ден на лятното слънцестоене
3 слънчеви десерта за 21 юни – ден на лятното слънцестоене  Комедийният феномен Sooshi Mango разсмя до сълзи българската публика
Комедийният феномен Sooshi Mango разсмя до сълзи българската публика 
 продава, Тристаен апартамент, 110 m2 София, Овча Купел, 360000 EUR
продава, Тристаен апартамент, 110 m2 София, Овча Купел, 360000 EUR  продава, Мезонет, 220 m2 София, Манастирски ливади Запад, 485000 EUR
продава, Мезонет, 220 m2 София, Манастирски ливади Запад, 485000 EUR  продава, Къща, 105 m2 София област, с.Гълъбовци, 49990 EUR
продава, Къща, 105 m2 София област, с.Гълъбовци, 49990 EUR  продава, Двустаен апартамент, 53 m2 Пловдив, Кършияка, 117900 EUR
продава, Двустаен апартамент, 53 m2 Пловдив, Кършияка, 117900 EUR  продава, Парцел, 1375 m2 Перник област, с.Кошарево, 34990 EUR
продава, Парцел, 1375 m2 Перник област, с.Кошарево, 34990 EUR  продава, Парцел, 8968 m2 Кюстендил област, гр.Сапарева Баня, 1500000 EUR
продава, Парцел, 8968 m2 Кюстендил област, гр.Сапарева Баня, 1500000 EUR 
 Нидерландия разби Швеция с 5:1 на Мондиала
Нидерландия разби Швеция с 5:1 на Мондиала  И тримата пострадали работници на АПИ са с опасност за живота
И тримата пострадали работници на АПИ са с опасност за живота  Седмичен хороскоп 22 юни - 28 юни 2026
Седмичен хороскоп 22 юни - 28 юни 2026  Зеленски върна отличието "Орден на Белия орел" на Полша
Зеленски върна отличието "Орден на Белия орел" на Полша  Утре настъпва Астрономическото лято
Утре настъпва Астрономическото лято  Цените на горивата у нас вървят надолу
Цените на горивата у нас вървят надолу 
 Човешкият ум може да не е уникален: Учени стигнаха до необичайни заключения
Човешкият ум може да не е уникален: Учени стигнаха до необичайни заключения  След 100 години: Физици обясниха „най-голямата грешка“ на Айнщайн
След 100 години: Физици обясниха „най-голямата грешка“ на Айнщайн  С какво биха се хранили извънземните на Земята?
С какво биха се хранили извънземните на Земята?  В Албания намериха уникално светилище на забравени богове
В Албания намериха уникално светилище на забравени богове  Откриха нов клас древни космически обекти в Млечния път
Откриха нов клас древни космически обекти в Млечния път  НАСА разширява партньорството си с частния сектор за сателитни данни
НАСА разширява партньорството си с частния сектор за сателитни данни 










